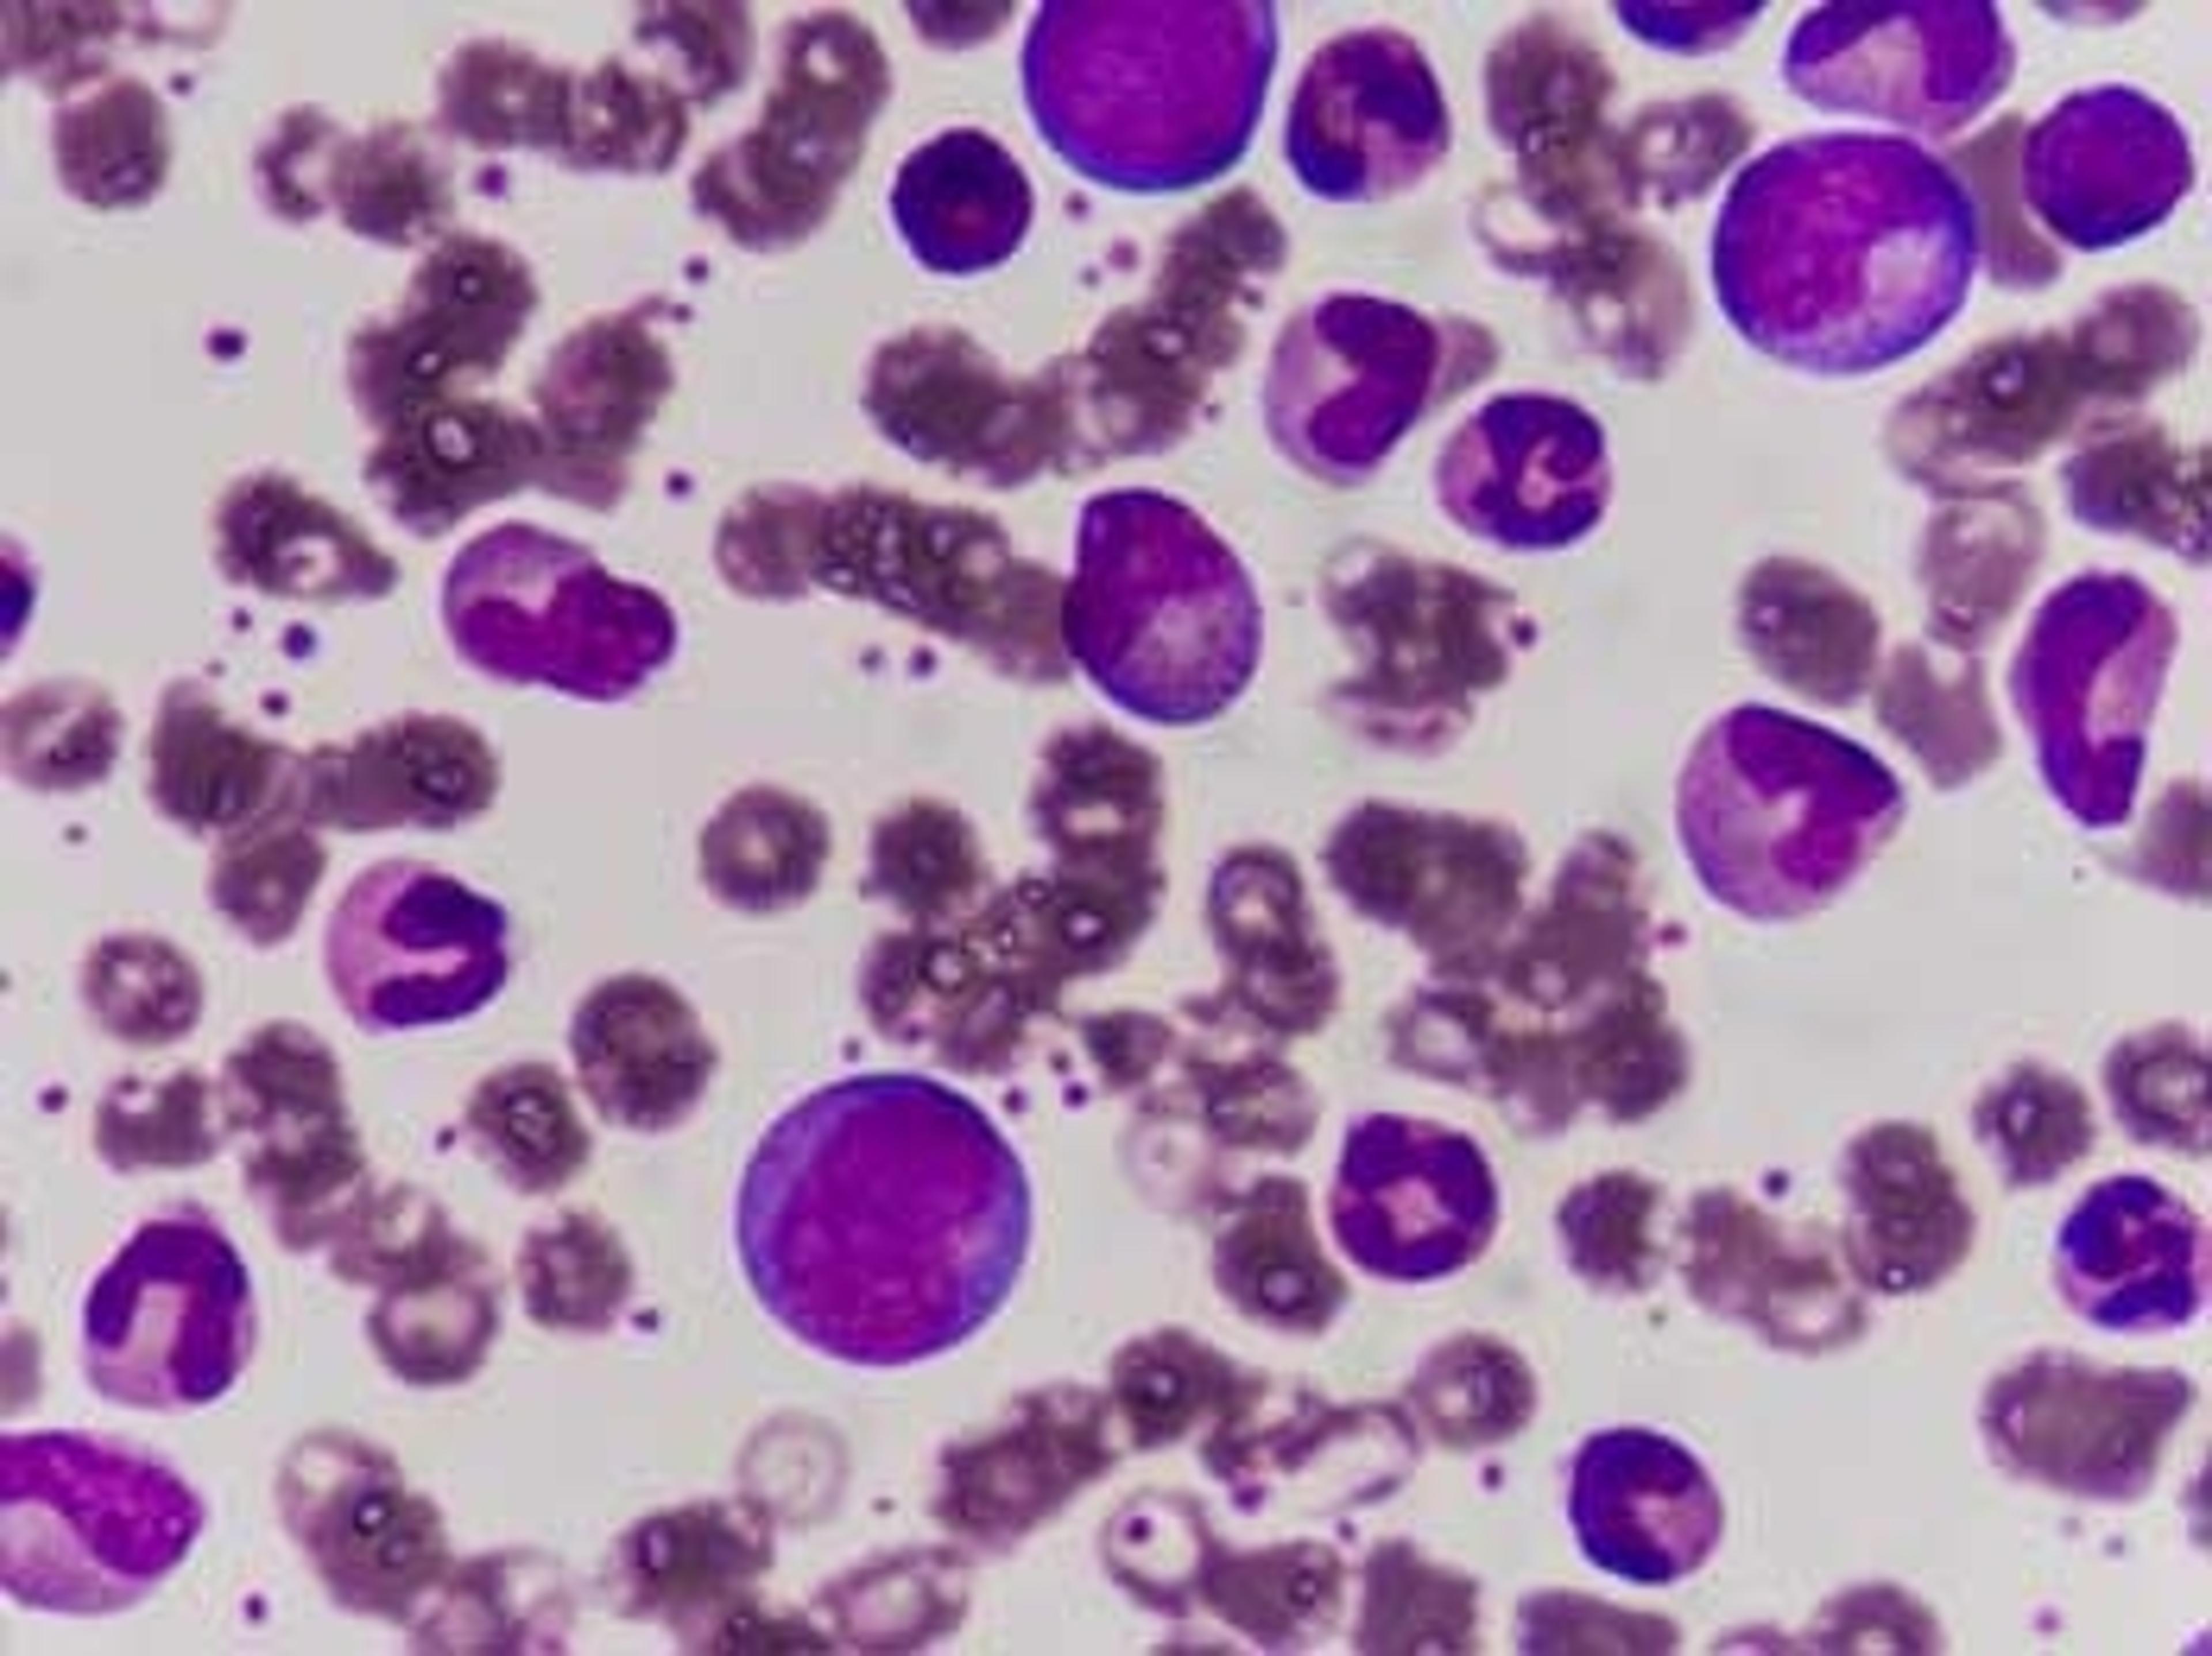

Multisizer 3 Coulter Counter
The Multisizer 3 is the next generation in particle sizing and counting.The most versatile particle sizing and counting analyser available today, the Multisizer 3 provides number, volume, mass, and surface area size distributions in one measurement, with an overall sizing range of 0.4 to 1200 microns.Whatever the industry – abrasives, pharmaceuticals, polymers or biological cell studies – you will get the ultra-high resolution…
Cell and particle size characterization
This instrument is very powerful but will need a lot of care in order to function well. The smaller apertures will clog unless the system is properly cleaned regularly and all liquids filtered. As a microfluidics lab we suffer a bit from the fact that you need to add your samples to a 100 ml reservoir (needing to unnecessary sample dilution). Some system components will need to be replaced after a couple of years and those are expensive. Sometimes you cannot purchase the part that needs to be replaced but need to buy an entire assembly at a much higher price than needed. However, as long as it's taken care of, you can get very nice size and concentration measurements down to around 700 nm. We have unfortunately not been able to go any smaller without clogging the system.
Review Date: 26 Feb 2015 | Beckman Coulter Diagnostics
Expensive but really useful.
Review Date: 28 Jun 2011 | Beckman Coulter Diagnostics
The Multisizer 3 is the next generation in particle sizing and counting.
The most versatile particle sizing and counting analyser available today, the Multisizer 3 provides number, volume, mass, and surface area size distributions in one measurement, with an overall sizing range of 0.4 to 1200 microns.
Whatever the industry – abrasives, pharmaceuticals, polymers or biological cell studies – you will get the ultra-high resolution, multiple channel analysis and accuracy you need. The response is unaffected by particle colour, shape,density, composition or refractive index.
Equally at home in a quality control environment or Research and Development laboratory, the Multisizer 3 Coulter Counter provides the analyst with a system which is easy to use, yet so technologically advanced that it is able to solve most particle sizing or counting problems.